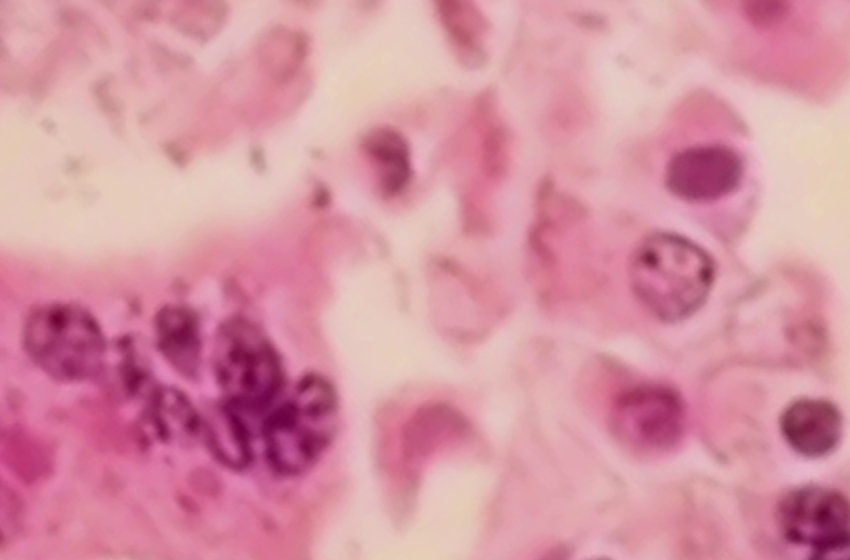
Measles outbreak in Michigan county as cases spread ‘like wildfire’

Measles outbreak in Michigan county as cases spread ‘like wildfire’
(FOX 2) – State officials have identified a measles outbreak in Washtenaw County after confirming three cases since March 12.
There are no known exposure sites in the state. All three cases are associated with travel from Florida, the Michigan Department of Health and Human Services said on Thursday.
However, with the illness in the state, the possibility of transmission increases, growing the likelihood of other cases.
What they’re saying:
The chief medical executive described measles as “spreading like wildfire” in 2026. Doctor Natasha Bagdasarian said the risk of spring break was increasing exposure.
“In this case, what happens on spring break does not stay on spring break,” Bagdasarian said. “Measles is incredibly transmissible and can easily travel home with us, infecting others in our schools and communities. The MMR (measles, mumps and rubella) vaccine remains our best defense, and two doses of MMR offer 97% protection against measles.”
Dig deeper:
The public is urged to get vaccinated against the illness, especially if they are traveling.
Since January, there have been more than 1,350 cases of measles across 31 states.
The health department added that the rate of vaccination had dropped in Michigan over the past year.
“Our team is working very hard to contain this outbreak as much as possible,” said Dr. Juan Luis Marquez, Washtenaw County Health Department medical director. “It saves valuable time and resources when people are fully protected through vaccination and allows us to focus where people may be vulnerable because they’re too young for vaccination, immunocompromised or pregnant.”
The Source: A news release from MDHHS was cited for this story.
First Appeared on
Source link






